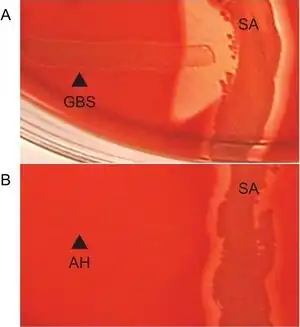

CAMP test
The CAMP test (Christie–Atkins–Munch-Peterson) is a test to identify group B β-hemolytic streptococci (Streptococcus agalactiae)[1][2]
Based on their formation of a substance (CAMP factor[3]) that enlarges the area of hemolysis formed by the β-hemolysin elaborated from Staphylococcus aureus.
CAMP factor
Although the test is usually used to identify group B streptococcus, there is some evidence that the CAMP factor gene is present in several groups of streptococci, including group A.[4]
A similar factor has been identified in Bartonella henselae.[5]
This is an example of a positive CAMP test indicated by the formation of an arrowhead where the Strep group B (Streptococcus agalactiae) meets the Staphylococcus aureus (light-yellow/golden middle streak).
Example of a workup algorithm of possible bacterial infection in cases with no specifically requested targets (non-bacteria, mycobacteria etc.), with most common situations and agents seen in a New England community hospital setting. CAMP test is shown at bottom left.
Uses
The CAMP test can be used to identify Streptococcus agalactiae. Though not strongly beta-hemolytic on its own,[6] group B strep presents with wedge-shaped colonies in the presence of Staphylococcus aureus.[7]
It can also be used to identify Listeria monocytogenes which produces a positive CAMP reaction.[8]
Setup
- Streak a beta-lysin–producing strain of aureus down the center of a sheep blood agar plate.
- The test organism streak should be 3 to 4 cm long.
- Streak test organisms across the plate perpendicular to the S. aureus streak within 2 mm. (Multiple organisms can be tested on a single plate).
- Incubate at 35°-37°C in ambient air for 18-24 hours.
- Wedge shaped pattern radiating from the test organism near the S. aureus indicates positivity
Reverse CAMP test
The reverse CAMP test is a method to identify Clostridium perfringens using β-hemolytic streptococci. The CAMP factor produced by S. agalactiae and the alpha toxin produced by C. perfringens act synergistically to produce enhanced hemolysis. Streaking these two organisms perpendicular to each other on a blood agar plate will yield a “bow tie” shaped zone of hemolysis which indicates a positive test.[9][10]
History
CAMP is an acronym for "Christie–Atkins–Munch-Peterson",[11][12][13] for the three researchers who discovered the phenomenon.[14]
It is often incorrectly reported as the product of four people (counting Munch-Petersen as two people).[15] The true relationship (three people) is the reason for two en dashes and then one hyphen in Christie–Atkins–Munch-Petersen.
The name of the test bears no relationship to the name of the second messenger cyclic adenosine monophosphate (commonly referred to as cAMP).
References
- ↑ Phillips EA, Tapsall JW, Smith DD (August 1980). "Rapid tube CAMP test for identification of Streptococcus agalactiae (Lancefield group B)". J. Clin. Microbiol. 12 (2): 135–7. PMC 273541. PMID 7014603.
- ↑ Wilkinson HW (July 1977). "CAMP-disk test for presumptive identification of group B streptococci". J. Clin. Microbiol. 6 (1): 42–5. PMC 274694. PMID 328534.
- ↑ "Laboratory Demonstrations". Archived from the original on September 28, 2008. Retrieved 2008-12-12.
- ↑ Gase K, Ferretti JJ, Primeaux C, McShan WM (September 1999). "Identification, cloning, and expression of the CAMP factor gene (cfa) of group A streptococci". Infect. Immun. 67 (9): 4725–31. PMC 96801. PMID 10456923.
- ↑ Litwin CM, Johnson JM (July 2005). "Identification, cloning, and expression of the CAMP-like factor autotransporter gene (cfa) of Bartonella henselae". Infect. Immun. 73 (7): 4205–13. doi:10.1128/IAI.73.7.4205-4213.2005. PMC 1168562. PMID 15972511.
- ↑ "Microbiology Primer: Hemolysis". Archived from the original on 2008-12-11. Retrieved 2008-12-12.
- ↑ "Streptococcaceae Answers". Archived from the original on 2008-10-05. Retrieved 2008-12-12.
- ↑ Aryal, Sagar. "CAMP Test- Principle, Uses, Procedure and Result Interpretation". Microbiology Info.com. Archived from the original on 2023-09-04. Retrieved 2019-09-04.
- ↑ Anne Hanson (2006-10-09). "CAMP Test Protocols" (PDF). American Society for Microbiology. Archived from the original (PDF) on 2023-02-18.
- ↑ Pratiksha Pokhrel (2015-09-24). "Reverse CAMP test for the identification of Clostridium perfringens". Microbiology Notes. Archived from the original on 2021-01-24.
- ↑ Ratner HB, Weeks LS, Stratton CW (August 1986). "Evaluation of spot CAMP test for identification of group B streptococci". J. Clin. Microbiol. 24 (2): 296–7. PMC 268893. PMID 3528214.
- ↑ Nsagha DS, Bello CS, Kandakai-Olukemi YT (January 2000). "Hippurate hydrolysis and Christie, Atkins, Munch-Peterson tests as epidemiological diagnostic tools for Streptococcus agalactiae carriage in pregnancy". East Afr Med J. 77 (1): 34–6. doi:10.4314/eamj.v77i1.46373. PMID 10944837.
- ↑ Valanne S, McDowell A, Ramage G, et al. (May 2005). "CAMP factor homologues in Propionibacterium acnes: a new protein family differentially expressed by types I and II". Microbiology. 151 (Pt 5): 1369–79. doi:10.1099/mic.0.27788-0. PMID 15870447.
- ↑ Christie, R., Atkins, NE and Munch-Petersen, E. (1944). A note on a lytic phenomenon shown by group B streptococci. Aust. J. Exp. Biol. Med. Sci. 22, 197-200
- ↑ "Streptococci". Archived from the original on 2023-09-04. Retrieved 2008-12-12.